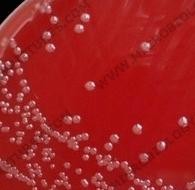

Материал: Литусов_Пиогенные кокки

ЛОС
Рисунок 2.9 – Сравнительная структура липополисахарида (ЛПС) и липоолигосахаридов (ЛОС).
По структуре ЛОС напоминает гликосфинголипид клеточной мембраны организма, поэтому микроб “маскируется” от действия защитных факторов макроорганизма. Кроме того, ЛОС-эндотоксин содержит нейраминовую (сиаловую) кислоту, что обеспечивает устойчивость менингококков к комплементу (блокирование альтернативного пути активации комплемента).
Менингококки не имеют жгутиков, спор не образуют. Они способны образовывать пили и капсулу (рисунок 2.10).

Рисунок 2.10 – Капсула и пили N. meningitidis. Заимствовано из Интернет-ресурсов.
Культуральные свойства. Менингококки являются строгими аэробами и капнофилами. Они очень требовательны к условиям культивирования и хорошо растут в присутствии 5-7% углекислого газа. На простых питательных средах менингококки не растут, для их культивирования используют среды, содержащие кровь, сыворотку крови, яичный желток, аминокислоты, витамины. Оптимальное значение рН среды составляет 7,2-7,4. Оптимальная температура выращивания 37°С. На плотной питательной среде менингококки образуют полупрозрачные
нежные колонии с ровными краями и блестящей поверхностью (S-форма) диаметром 0,5-1,5 мм. На кровяном агаре формируются полупрозрачные сероватые колонии маслянистой консистенции без зоны гемолиза (рисунок 2.11).

Рисунок 2.11 – Рост менингококков на кровяном агаре. Заимствовано из Интернет- ресурсов.
В столбике 0,1% полужидкого сывороточного агара менингококк вызывает интенсивное помутнение в верхней части столбика.
В сывороточном бульоне менингококки вызывают гомогенное помутнение ближе к поверхности среды.
Биохимическая активность менингококков низкая. Они разлагают глюкозу и мальтозу до кислоты без газа (рисунок 2.12), не разжижают желатин, не образуют индол и сероводород, не восстанавливают нитраты.
Глюкоза Мальтоза Лактоза Сахароза
Рисунок 2.12 – Разложение углеводов менингококками.
Антигенная структура. По капсульным антигенам менингококки подразделяются на 13 серологических групп (А, В, С, D, 29-Е, Н, I, К, L, X, Y, Z, W- 135). Наиболее часто от больных выделяют серогруппы А, В и С. Штаммы серогруппы А вызывают эпидемические вспышки, а штаммы серогрупп В и С выделяются при спорадических заболеваниях.
В клеточной мембране менингококков содержится нейссериальный видоспецифический поверхностный белок А (NspA) и поверхностные типоспецифические белки 5 классов (класс 1 - PorA, классы 2 и 3 - PorB, класс 4 - Rmp и класс 5 – Opa и Орс). Часть этих белков выполняет функцию поринов (PorA и PorB). Белки наружной мембраны класса 5 (Ора и Орс) называются белками мутности, так как штаммы, имеющие эти белки, формируют мутные колонии.
На основании типоспецифических белков вид N. meningitidis делят на
серотипы (по PorB-белку выделяют 20 серотипов). В свою очередь, по составу
белков класса 1 (по PorA-белку) серотипы подразделяются на 10 субтипов. Одни
и те же типовые и субтиповые белки встречаются у менингококков разных серогрупп. Таким образом, антигенный состав каждого штамма включает капсульный групповой полисахарид, типовой белок и субтиповой белок. В практической работе изучение антигенной структуры штаммов ограничивается определением серогруппы, реже – серотипа и субтипа. Типовые и субтиповые антигены используются в качестве эпидемических маркеров штаммов менингококков.
Липоолигосахариды клеточной стенки N. meningitidis в антигенном отношении неоднородны, в результате чего менингококки подразделяются на иммунотипы (L1, L2, L3 и т. д.).
К факторам патогенности менингококков относятся пили, поверхностные белки (белки наружной мембраны), “железо-обеспечивающие” белковые системы, полисахаридная капсула, ЛОС-эндотоксин, гиалуронидаза, нейраминидаза, протеаза и другие факторы (рисунок 2.13).
 Нейраминидаза
Нейраминидаза
Rmp
Капсула
Ора
Протеаза Пили
Гиалуронидаза
Por
ЛОС
Орс
Рисунок 2.13 – Основные факторы патогенности менингококков.
Пили обеспечивают адгезию возбудителя к слизистой оболочке носоглотки. За адгезию и поверхностную колонизацию носоглоточного эпителия отвечает концевой ассоциированный с пилями белок PilC. Рецептором для этого белка служит CD46, имеющийся на эпителиальных клетках и специфичный только для человека. Белок PilC “оповещает” менингококк об адгезии. В эпителиальной клетке под местом прикрепления PilC происходит перестройка цитоскелета. После получения сигнала от белка PilC о прикреплении бактерии к эпителиальной клетке менингококки убирают пили путем ретракции (сокращения) и утрачивают капсулу. В результате этого происходит непосредственное соприкосновение менингококка своей наружной мембраной с поверхностной мембраной эпителиальной клетки.
Белки наружной мембраны PorA и PorB (порины), Rmp M (reduction modifiable protein), Opa (A, B, D), Opc выполняют у менингококков функции адгезии и инвазии. При этом белки мутности Ора и Орс участвуют в адгезии микробных клеток, а белок Орс является еще и инвазином, отвечающим за проникновение менингококков в эпителиальные клетки. Белки Opa A и D способствуют адгезии бактерий к эпителию и эндотелию путем взаимодействия с рецептором СD66. Белки наружной мембраны PorA и PorB встраиваются в мембрану эпителиальных клеток и образуют ионные каналы. Белок PorB участвует в реорганизации актина эпителиальных клеток, что способствует инвазии микробной клетки.
Капсула полисахаридной природы защищает от фагоцитоза ме- нингококки, находящиеся в кровяном русле.
“Железо-обеспечивающие” белковые системы располагаются в наружной мембране менингококков и объединяют белки, конкурирующие за ионы железа:
лактоферрин-связывающие белки (LbpA и LbpB);
трансферрин-связывающие белки (TbpA и TbpB);
гемоглобин-связывающие белки (HbmR и HpuA/B).
Эти белки участвуют в метаболизме железа. У разных штаммов менингококков они различаются по молекулярной массе и свойствам.
Эндотоксин (ЛОС) оказывает выраженное пирогенное и сенсибилизирующее действие, участвует в развитии сосудистых поражений и кровоизлияний во внутренние органы. Результатом этого действия является экзантема в виде характерной геморрагической сыпи. Выраженная токсинемия возникает при размножении менингококков в кровяном русле.
Гиалуронидаза, нейраминидаза и фибринолизин способствуют распространению возбудителя по организму.
Протеаза (IgA-протеаза) расщепляет секреторный иммуноглобулин А в шарнирной области, защищая бактерии от действия антител.
Резистентность. Менингококки слабоустойчивы во внешней среде. Вне организма человека и при низкой температуре они быстро погибают. Поэтому при доставке материала в лабораторию используют не только специальную транспортную среду, но и транспортировочные контейнеры, обеспечивающие заданный температурный режим. При температуре 10°С менингококки погибают через 2 часа, при температуре 55°С - через 5 минут, при 80°С – через 1-2 минуты, при кипячении - моментально. Ультрафиолетовые лучи оказывают на них летальное действие. Менингококки чувствительны к действию большинства антисептиков и дезинфектантов. Под действием 1% раствора фенола, 0,5-1% раствора хлорамина, 70% этанола, 3-5% раствора карболовой кислоты они погибают через 1 минуту. Большинство антибиотиков оказывает на менингококки бактерицидное действие. Однако менингококк обладает естественной резистентностью к ванкомицину, полимиксину, ристомицину, линкомицину.
Эпидемиология. Источником возбудителя при менингококковой инфекции являются больные генерализованными формами (около 1% от общего числа инфицированных лиц), больные назофарингитом (10-20% от общего числа инфицированных лиц) и здоровые носители (80-90% от числа инфицированных). Бактерионосительство у детей 1-2 лет встречается редко, чаще всего носительство отмечается в возрасте 14-19 лет. Бактерионосительство продолжается в течение 2-3 недель. Механизм передачи - аэрогенный, путь передачи - воздушно-капельный. Менингококковый менингит регистрируется в осенне-зимний период.
Менингококковой инфекцией болеют в основном дети до 15 лет (70-80%) и лица юношеского возраста (10-15%). Возникновению вспышек способствует скученность детей в детских организованных коллективах, учащихся в школах, студентов. Уровень заболеваемости зависит от распространенности носительства менингококка: заболевания не регистрируются в коллективах, где носительство составляет 20% и выше. В этих случаях интенсивная циркуляция менингококка обеспечивает “естественную иммунизацию” людей.
В настоящее время менингококковая инфекция зарегистрирована более
чем в 150 странах мира. В Африке имеется зона высокой заболеваемости менингококковой инфекцией (“менингитный пояс”). Эта зона располагается к югу от пустыни Сахара и распространяется от Эфиопии на востоке до Гамбии на западе. Она включает 15 стран и население более 260 млн. человек (рисунок 2.14).
Эпидемии менингококкового менингита происходят в этих странах через каждые 7-14 лет. В этой зоне регистрируются высокие показатели заболеваемости менингококковой инфекцией. Например, за эпидемический сезон 2009 г. в 14 странах было зарегистрировано 88199 случаев заболевания, из которых 5352 случая закончились летальным исходом.

Рисунок 2.14 - “Менингитный пояс” в Африке. Заимствовано из Интернет-ресурсов. Заболеваемость менингококковой инфекцией в Российской Федерации за
1998-2002 годы составила 2,7 на 100 тыс. населения, в 2003 г. показатель заболеваемости составил 3,01 на 100 тыс. населения. За 2007-2009 гг. число генерализованных форм менингококковой инфекции по Российской Федерации снизилось с 2246 случаев (1,58 на 100 тыс. населения) до 1795 случаев (1,26 на 100 тыс. населения), а число летальных исходов – с 293 до 239 случаев.
Патогенез менингококковой инфекции включает несколько этапов (рисунок 2.15). На первом этапе менингококки, проникнув в организм человека с вдыхаемым воздухом, попадает на слизистую оболочку носоглотки (входные ворота инфекции). Нейраминидаза способствует продвижению возбудителя через слой вязкой слизи, а IgA-протеаза разрушает секреторный иммуноглобулин А на слизистой оболочке. Затем менингококк с помощью пилей связывается с рецепторами CD46 эпителиоцитов и колонизирует слизистую оболочку. На стадии колонизации возбудитель не образует капсулу. В этот период в месте входных ворот не возникает выраженных морфологических изменений, поэтому процесс называют “здоровым” носительством. В большинстве случаев колонизация длится от 1 недели до 1 месяца и прекращается благодаря действию защитных сил организма.
Большое значение в колонизации слизистых оболочек имеет способность менингококков формировать биопленку. Она состоит из экзополисахаридного волокнистого матрикса и содержит канальцы, обеспечивающие питанием находящиеся в матриксе бактерии. Менингококковая биопленка образуется на поверхности эпителия в течение 12 часов после проникновения возбудителя в организм. Находящиеся в биопленке клетки лишены капсул. Друг с другом бактерии
в биопленке сцеплены с помощью пилей. Биопленка защищает микробные клетки от антител, лекарственных препаратов и других неблагоприятных факторов окружающей среды. От поверхностных слоев биопленки периодически могут “отрываться” отдельные бактерии (так называемые планктонные клетки). Такие клетки могут образовывать капсулу. Следовательно, носительство обусловлено как капсульными, так и бескапсульными клетками, временно прекратившими синтез капсульной субстанции.
 Менингококковый
назофарингит
Менингококковый
назофарингит
Бактериемия (менингококкемия)
Гнойный менингит
Рисунок 2.15 – Схема патогенеза менингококковой инфекции.
Примерно у 30-50% бактерионосителей инфекционный процесс переходит в следующий этап – инвазия микробов в подслизистый слой. В этом случае бескапсульные менингококки “убирают” пили и клеточной стенкой соприкасаются с поверхностной мембраной эпителиальной клетки. Затем с помощью поверхностных белков Ора и Орс менингококк прикрепляется к мембране эпителиальных клеток и внедряется в них путем инвагинации (фагоцитоз путем сигналинга). Те менингококки, которые сохранили капсулу, проникают в эпителиальные клетки путем “непрофессионального” фагоцитоза (поглощение бактерии эпителиальной клеткой по механизму эндоцитоза). Проникшие в эпителиальные клетки менингококки стимулируют выброс цитокинов, которые вызывают воспаление слизистой оболочки. Поглощенные менингококки транспортируются сквозь эпителиальную клетку в субэпителиальный слой (трансцитоз). В месте входных ворот (в носоглотке) развивается катаральное воспаление. При этом в кровь проникает эндотоксин, обусловливая интоксикацию организма, которая длится в течение 3-7 дней. Это состояние называется острым менингококковым назофарингитом.
У незначительной части инфицированных лиц менингококк, проникнув в кровь, вызывает бактериемию. Генерализованную инфекцию обусловливают капсульные клетки, имеющие пили. В кровяном русле часть клеток погибает, а другие начинают усиленно размножаться. В результате гибели клеток в кровоток поступает эндотоксин (эндотоксинемия), а быстрое размножение возбудителя приводит к бактериемии. При бактериемии происходит гематогенная диссеминация менингококков в различные органы и системы. В местах оседания возбудителя
формируются очаги гнойного воспаления. Развивается сепсис, известный как менингококцемия (менингококкемия). Эндотоксин возбудителя угнетает фагоцитарную активность нейтрофилов, усиливает свертывание крови, активирует систему комплемента и образование цитокинов (α-ФНО, ИЛ-1, ИЛ-6, ИЛ-8, ИЛ-10). Эндотоксинемия приводит к незавершенности фагоцитоза, вазодилатации, тромбообразованию в мелких капиллярах, множественным кровоизлияниям в слизистых оболочках, коже и внутренних органах. При резком нарушении свертывающей системы крови вначале увеличивается содержание фибриногена, затем происходит выпадение фибрина в мелких сосудах с образованием тромбов. Снижение содержания фибриногена в крови является причиной кровотечений и кровоизлияний в различные органы и ткани.
Попав в головной мозг, менингококки с помощью пилей прикрепляются к эндотелию сосудов мягкой и паутинной оболочек, а с помощью белка Орс проходят сквозь эндотелий. Так происходит преодоление менингококком гематоэнцефалического барьера. Проникновение возбудителя из крови в ЦНС вызывает воспаление мозговых оболочек. Воспаление носит вначале серозный, а затем - гнойный характер (гнойный менингит). В субарахноидальном пространстве менингококки размножаются. Воспалительный процесс вызывает чрезмерное образование спинномозговой жидкости, приводящее к повышению внутричерепного давления и отеку головного мозга.
В патогенезе генерализованной менингококковой инфекции кроме бактериемии и интоксикации большую роль играет развитие гиперчувствительности замедленного типа, что выражается накоплением циркулирующих иммунных комплексов, которые обусловливают клиническую картину миокардита, перикардита, артрита.
Необходимо отметить, что для клинических штаммов (штаммов, вызывающих заболевание) характерно наличие капсулы, наличие белков-поринов в составе внешней мембраны и отсутствие пилей, тогда как для штаммов, выделенных от бактерионосителей, характерно отсутствие капсулы, низкая экспрессия белков- поринов и наличие пилей.
Клиника. Менингококковая инфекция клинически протекает в виде первично-локализованных форм (менингококконосительство, острый назофарингит) или в виде генерализованных форм (менингококцемия или менингококкемия, менингококковый сепсис, менингококковый менингит, менингоэнцефалит). При генерализованных формах возможно развитие эндокардита, артрита, полиартрита, иридоциклита, пневмонии.
Менингококковый назофарингит проявляется повышением температуры тела до 38ОС, насморком, болью в горле, головной болью. При этом кожа остается бледной и сухой.